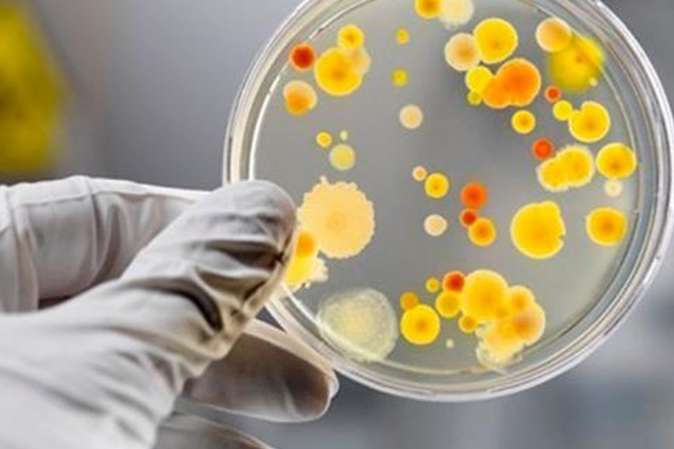

У Білоцерківському та Бориспільському районах Київщини минулої ночі на пожежах загинуло двоє людей
Вночі, 6 грудня, рятувальники Бориспільщини та Білоцерківщини в Київській області двічі виїжджали на гасіння пожеж. В обох випадках на місцях подій було виявлено тіла загиблих. Рятувальники нагадали, що з початку 2021 року на території Київської області виникло 6752 пожеж. В результаті загинула 61 особа та 219 травмовано. kievvlast.com.ua »